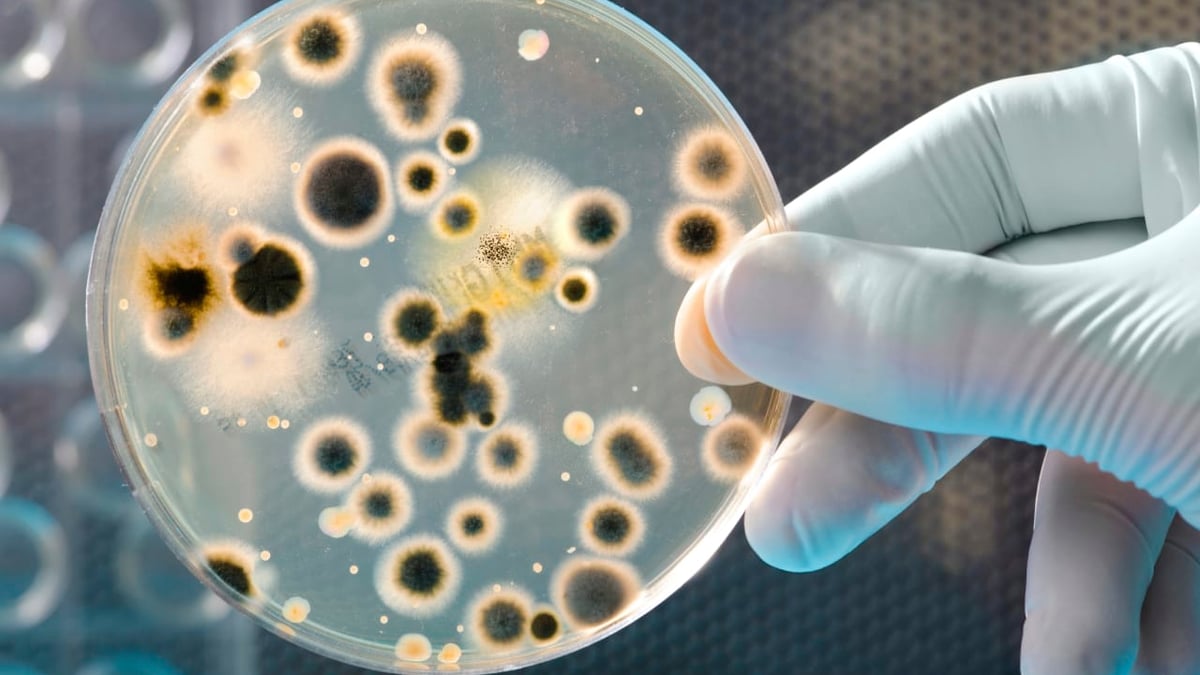

Avföringstransplantation prövas på brännskadade i världsunik studie på Akademiska
Svårt brännskadade som vårdas på sjukhus behöver ofta starka, breda antibiotika som förändrar tarmfloran och ökar risken att drabbas av infektioner orsakade av resistenta bakterier. I mitten av december inleds en studie på brännskadecentrum vid Akademiska sjukhuset, en av de första i sitt slag i världen som fokuserar på sambandet mellan antibiotika, resistenta bakterier, tarmflora och nyttan av behandling med avföringstransplantation hos denna patientgrupp.
Publicerad 2015-12-17 • Pressmeddelande

– Risken att drabbas av infektioner med resistenta bakterier är hög hos svårt brännskadade. De har ofta stora sår och saknar hudlager som normalt fungerar som en skyddande barriär. Dessutom vårdas patienterna ofta länge i respirator inom intensivvården. Sårinfektioner och blodförgiftning är vanligt förekommande, säger Hanna Montelin, infektionsläkare på Akademiska sjukhuset och doktorand vid Uppsala universitet.
Främsta syftet med patientstudien, menar hon är att se hur tarmfloran och förekomsten av resistenta bakterier förändras under vårdtiden. Forskarna vill även undersöka hur antibiotikabehandling påverkar tarmfloran och effekter av behandling med avföringstransplantation, så kallad fecestransplantation, efter avslutad antibiotikabehandling. Studien görs i samarbete med infektionskliniken och beräknas pågå under två år.
Under senare år har kopplingen mellan tarmflorans sammansättning och förhöjd risk att drabbas av övervikt, hjärt-kärlsjukdomar och diabetes blivit allt tydligare. Sambandet mellan tarmflora, resistenta bakterier, antibiotikabehandling och infektionskänslighet hos brännskadade patienter är däremot mindre utforskat. Men en nyligen publicerad studie har bekräftat att tarmfloran påverkas vid allvarliga brännskador och att det finns ett samband mellan graden av rubbad tarmflora, omfattningen av inflammation och organsvikt. Slutsatsen är att patienter som har en mer intakt tarmflora kan ha ett mer välfungerat immunförsvar och därmed bättre skydd mot blodförgiftning med problem med organfunktion.
I studien kommer tarmfloran undersökas vid ankomst, utskrivning och efter utskrivning. En del av avföringsproverna skickas till mikrobiologen på Akademiska sjukhuset för analys av multiresistenta bakterier. Den andra delen fryses ned och skickas till Scilifelab i Stockholm för kartläggning av tarmflorans sammansättning med hjälp av nya sekvenseringstekniker. En grupp patienter kommer dessutom att få ett lavemang baserat på deras egen ursprungliga avföring i syfte att återskapa normal bakterieflora. Det är första gången sådan behandling ges till brännskadepatienter. Den har tidigare visat sig framgångsrik vid behandling av diarré orsakad av bakterien Clostridium difficile.
– Den som får en rubbad tarmflora och blir bärare av antibiotikaresistenta bakterier kan få problem senare, till exempel med svårbehandlade infektioner. Därför är det värdefullt att se om denna patientgrupp kan ha nytta av transplantationsbehandling, säger Hanna Montelin.
Mer information:
Hanna Montelin, doktorand och infektionsläkare Akademiska sjukhuset, 018-611 17 21
Thomas Grenholm Tängdén, infektionsläkare och forskare vid Uppsala universitet, 018-471 6613
Fredrik Huss, överläkare brännskadecentrum, 018-611 37 57 eller 0738-670483
Bildtext: Agarplatta med odlade bakterier (Istockphoto)
FAKTA: Tarmflorestudie på brännskadepatienter, Akademiska sjukhuset
* Startar i mitten av december på brännskadecentrum, Akademiska sjukhuset.
* Beräknas pågå under två år och inkludera 40-50 patienter över 18 år som vårdas inneliggande för svåra brännskador.
* Hos samtliga kommer tarmfloran undersökas både vid ankomst, utskrivning samt 1, 3 och 6 månader efter utskrivningen. Vid inskrivningen tas ett avföringsprov för undersökning av förekomst av multiresistenta bakterier och tarmflorans sammansättning. * Vissa patienter kommer fyra veckor efter utskrivning att få ett lavemang med den egna ursprungliga tarmfloran som kan återskapa en normal bakterieflora.